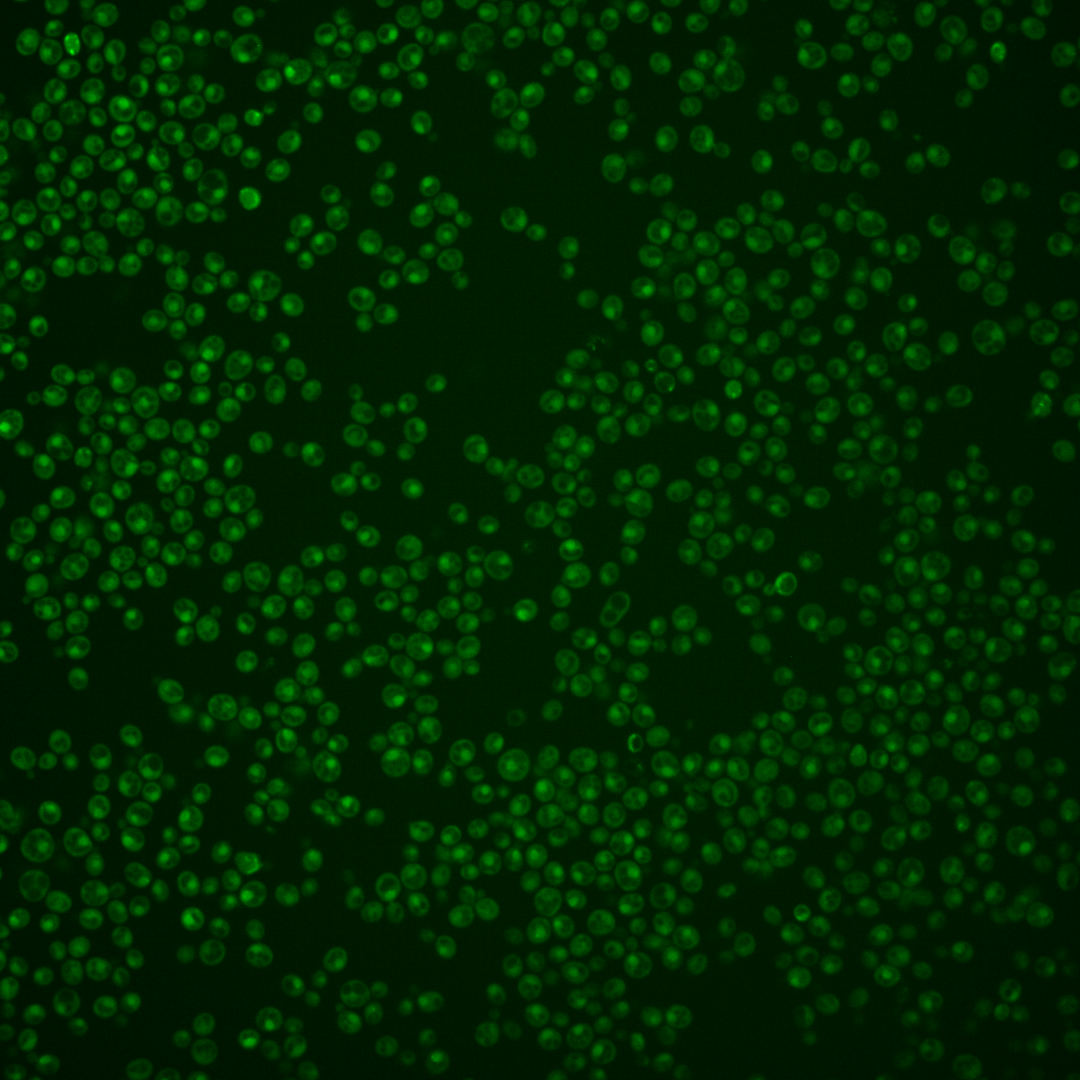
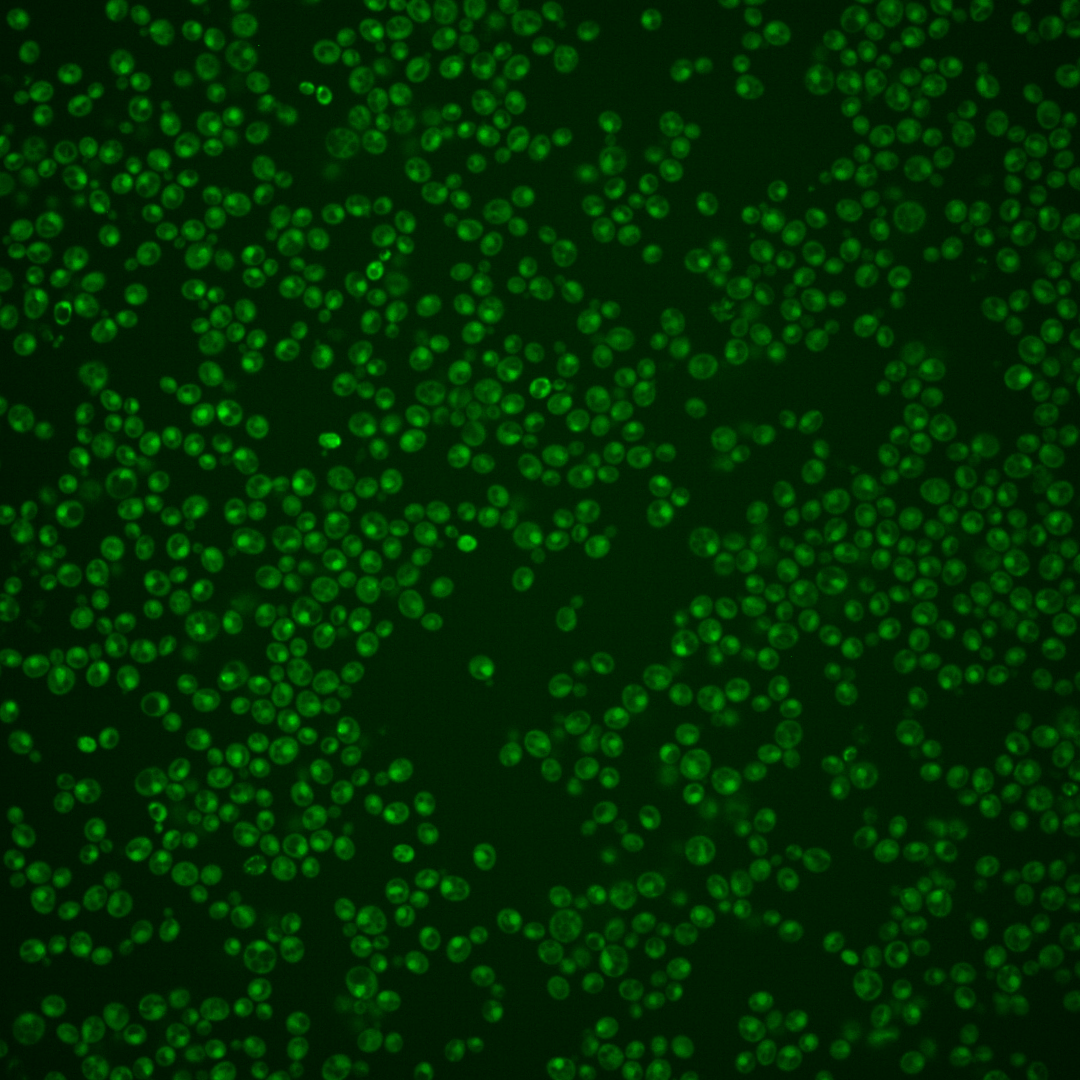
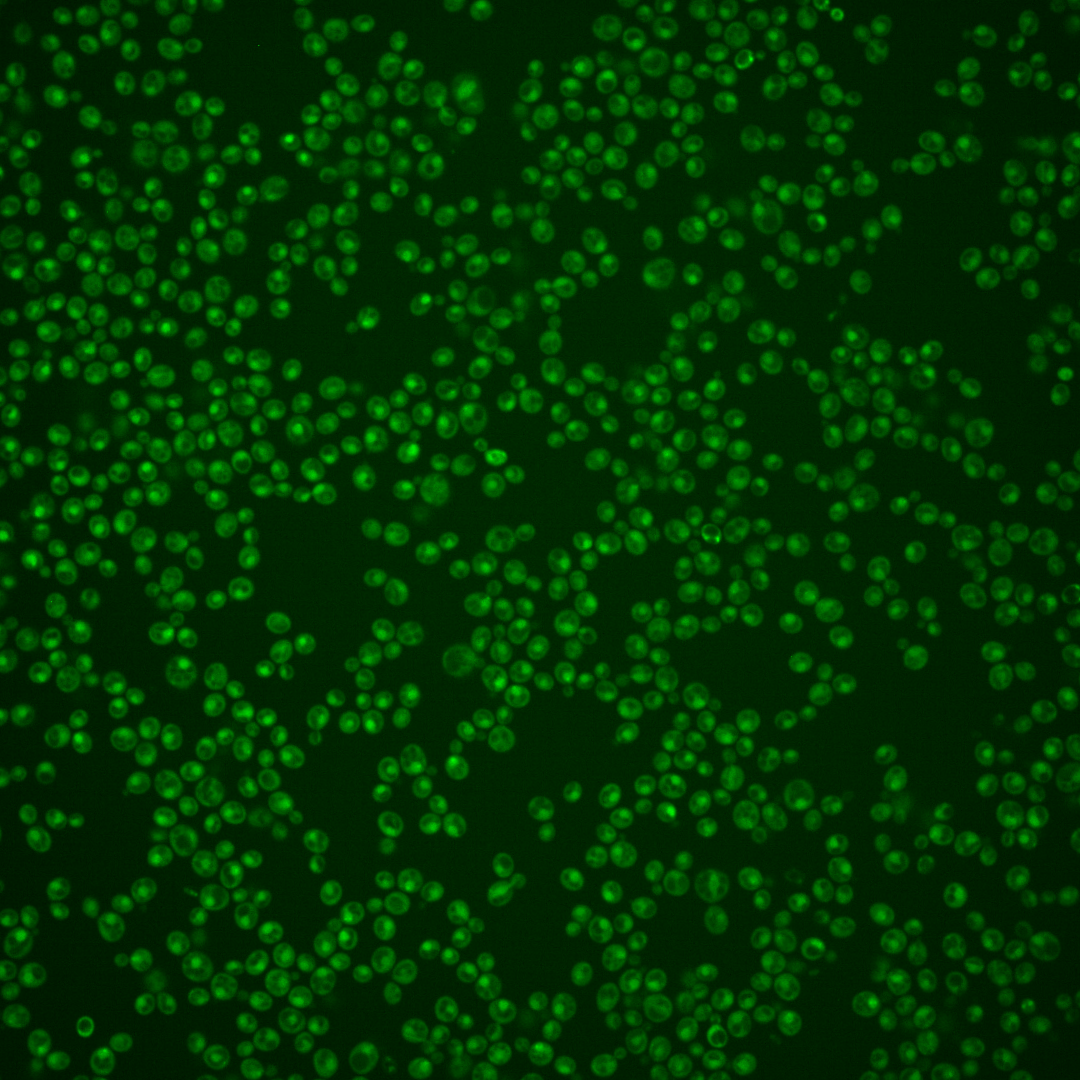

| Standard name | |
|---|---|
| Human Ortholog | |
| Description | Subunit of cohesin loading factor (Scc2p-Scc4p); complex is required for the loading of cohesin complexes onto chromosomes; involved in establishing sister chromatid cohesion during double-strand break repair via phosphorylated histone H2AX |
Micrographs




















































































Sub-cellular Localization
Yeast GFP Assignment
Protein Abundance
Localization Change
External localization resources
| ensLOC | DeepLoc | |||||||||||||||||||||||
|---|---|---|---|---|---|---|---|---|---|---|---|---|---|---|---|---|---|---|---|---|---|---|---|---|
| Localization | WT1 | WT2 | WT3 | RAP60 | RAP140 | RAP220 | RAP300 | RAP380 | RAP460 | RAP540 | RAP620 | RAP700 | HU80 | HU120 | HU160 | rpd3Δ_1 | rpd3Δ_2 | rpd3Δ_3 | WT1 | WT2 | WT3 | AF100 | AF140 | AF180 |
| Cortical Patches | 0 | 0 | – | 0 | 0 | 0 | 0 | – | 0 | 0 | 0 | 0 | 0 | 0 | 0 | 0 | 0 | 0 | 0 | 0 | 0 | 0 | 0 | 0 |
| Bud | 1 | 0 | – | 0 | 0 | 1 | 0 | – | 0 | 0 | 3 | 0 | 0 | 0 | 0 | 0 | 0 | 1 | 1 | 1 | 1 | 0 | 2 | 1 |
| Bud Neck | 0 | 0 | – | 1 | 3 | 1 | 1 | – | 0 | 3 | 0 | 2 | 0 | 0 | 2 | 0 | 0 | 0 | 0 | 0 | 0 | 0 | 1 | 1 |
| Bud Site | 0 | 0 | – | 0 | 0 | 1 | 4 | – | 1 | 2 | 5 | 4 | 0 | 0 | 0 | 0 | 0 | 1 | – | – | – | – | – | – |
| Cell Periphery | 0 | 0 | – | 0 | 0 | 0 | 1 | – | 0 | 0 | 0 | 0 | 0 | 0 | 0 | 0 | 1 | 0 | 0 | 0 | 0 | 0 | 0 | 0 |
| Cytoplasm | 14 | 16 | – | 30 | 23 | 49 | 50 | – | 17 | 27 | 13 | 16 | 9 | 45 | 51 | 7 | 10 | 25 | 7 | 4 | 2 | 2 | 13 | 22 |
| Endoplasmic Reticulum | 0 | 2 | – | 1 | 0 | 0 | 2 | – | 0 | 0 | 0 | 2 | 1 | 0 | 0 | 4 | 4 | 6 | 0 | 0 | 0 | 0 | 0 | 0 |
| Endosome | 0 | 1 | – | 1 | 8 | 7 | 5 | – | 0 | 4 | 2 | 0 | 1 | 1 | 2 | 3 | 4 | 7 | 3 | 4 | 0 | 0 | 0 | 0 |
| Golgi | 0 | 0 | – | 0 | 0 | 0 | 0 | – | 0 | 0 | 0 | 0 | 0 | 0 | 1 | 2 | 0 | 2 | 0 | 2 | 0 | 0 | 0 | 0 |
| Mitochondria | 75 | 3 | – | 7 | 3 | 35 | 69 | – | 92 | 80 | 121 | 105 | 8 | 1 | 3 | 3 | 2 | 4 | 1 | 2 | 4 | 0 | 3 | 8 |
| Nucleus | 160 | 97 | – | 96 | 77 | 84 | 156 | – | 85 | 132 | 84 | 148 | 29 | 106 | 89 | 43 | 34 | 46 | 168 | 118 | 25 | 18 | 64 | 68 |
| Nuclear Periphery | 0 | 0 | – | 0 | 0 | 0 | 1 | – | 0 | 0 | 0 | 0 | 0 | 0 | 0 | 0 | 0 | 1 | 1 | 0 | 0 | 0 | 0 | 0 |
| Nucleolus | 3 | 3 | – | 0 | 2 | 2 | 3 | – | 2 | 5 | 4 | 4 | 0 | 0 | 0 | 1 | 1 | 0 | 9 | 3 | 0 | 0 | 0 | 1 |
| Peroxisomes | 0 | 0 | – | 0 | 0 | 0 | 0 | – | 0 | 0 | 0 | 0 | 0 | 0 | 0 | 0 | 0 | 0 | 0 | 0 | 0 | 0 | 0 | 0 |
| SpindlePole | 1 | 1 | – | 5 | 15 | 3 | 15 | – | 1 | 11 | 3 | 2 | 1 | 2 | 4 | 0 | 1 | 2 | 12 | 8 | 0 | 0 | 3 | 5 |
| Vac/Vac Membrane | 23 | 45 | – | 7 | 26 | 32 | 21 | – | 12 | 10 | 11 | 8 | 4 | 5 | 11 | 11 | 18 | 13 | 44 | 25 | 24 | 8 | 41 | 67 |
| Unique Cell Count | 223 | 147 | 141 | 145 | 185 | 272 | 163 | 215 | 170 | 217 | 43 | 154 | 151 | 68 | 62 | 97 | 256 | 174 | 64 | 31 | 135 | 183 | ||
| Labelled Cell Count | 277 | 168 | 148 | 157 | 215 | 328 | 210 | 274 | 246 | 291 | 53 | 160 | 163 | 74 | 75 | 108 | 256 | 174 | 64 | 31 | 135 | 183 | ||
Yeast GFP Assignment
Protein Abundance
| Screen | WT1 | WT2 | WT3 | RAP60 | RAP140 | RAP220 | RAP300 | RAP380 | RAP460 | RAP540 | RAP620 | RAP700 | HU80 | HU120 | HU160 | rpd3Δ_1 | rpd3Δ_2 | rpd3Δ_3 | AF100 | AF140 | AF180 |
|---|---|---|---|---|---|---|---|---|---|---|---|---|---|---|---|---|---|---|---|---|---|
| Mean Cell GFP Intensity (1e-4) | 4.0 | 4.9 | – | 5.1 | 5.7 | 4.6 | 4.6 | – | 3.9 | 4.3 | 3.8 | 3.8 | 5.2 | 5.4 | 5.5 | 7.9 | 7.2 | 7.1 | – | 5.1 | 5.3 |
| Std Deviation (1e-4) | 0.5 | 0.7 | – | 1.0 | 1.6 | 1.5 | 1.3 | – | 1.3 | 1.2 | 1.5 | 0.7 | 1.1 | 0.8 | 1.6 | 3.4 | 1.7 | 2.4 | – | 1.1 | 1.0 |
| Intensity Change (Log2) | – | – | – | – | – | – | – | – | – | – | – | – | – | – | – | – | – | – | – | – | – |
Localization Change
| Localization | RAP60 | RAP140 | RAP220 | RAP300 | RAP380 | RAP460 | RAP540 | RAP620 | RAP700 | HU80 | HU120 | HU160 | rpd3Δ_1 | rpd3Δ_2 | rpd3Δ_3 |
|---|---|---|---|---|---|---|---|---|---|---|---|---|---|---|---|
| Actin | – | – | – | – | – | – | – | – | – | – | – | – | – | – | – |
| Bud | – | – | – | – | – | – | – | – | – | – | – | – | – | – | – |
| Bud Neck | – | – | – | – | – | – | – | – | – | – | – | – | – | – | – |
| Bud Site | – | – | – | – | – | – | – | – | – | – | – | – | – | – | – |
| Cell Periphery | – | – | – | – | – | – | – | – | – | – | – | – | – | – | – |
| Cyto | – | – | – | – | – | – | – | – | – | – | – | – | – | – | – |
| Endoplasmic Reticulum | – | – | – | – | – | – | – | – | – | – | – | – | – | – | – |
| Endosome | – | – | – | – | – | – | – | – | – | – | – | – | – | – | – |
| Golgi | – | – | – | – | – | – | – | – | – | – | – | – | – | – | – |
| Mitochondria | – | – | – | – | – | – | – | – | – | – | – | – | – | – | – |
| Nuclear Periphery | – | – | – | – | – | – | – | – | – | – | – | – | – | – | – |
| Nuc | – | – | – | – | – | – | – | – | – | – | – | – | – | – | – |
| Nucleolus | – | – | – | – | – | – | – | – | – | – | – | – | – | – | – |
| Peroxisomes | – | – | – | – | – | – | – | – | – | – | – | – | – | – | – |
| SpindlePole | – | – | – | – | – | – | – | – | – | – | – | – | – | – | – |
| Vac | – | – | – | – | – | – | – | – | – | – | – | – | – | – | – |
| Cortical Patches | – | – | – | – | – | – | – | – | – | – | – | – | – | – | – |
| Cytoplasm | – | – | – | – | – | – | – | – | – | – | – | – | – | – | – |
| Nucleus | – | – | – | – | – | – | – | – | – | – | – | – | – | – | – |
| Vacuole | – | – | – | – | – | – | – | – | – | – | – | – | – | – | – |
External localization resources
Images






























Protein Concentration and Protein Localization Data
| R1 | R2 | R3 | ||||||||||||||||
|---|---|---|---|---|---|---|---|---|---|---|---|---|---|---|---|---|---|---|
| G1 Pre-START | G1 Post-START | S/G2 | Metaphase | Anaphase | Telophase | G1 Pre-START | G1 Post-START | S/G2 | Metaphase | Anaphase | Telophase | G1 Pre-START | G1 Post-START | S/G2 | Metaphase | Anaphase | Telophase | |
| Concentration | -0.7626 | -0.641 | -0.8246 | -1.0618 | -0.5592 | -0.8644 | -0.3312 | 0.1005 | 0.1106 | -0.2119 | 0.1791 | -0.1354 | -1.1264 | -1.167 | -1.1426 | -0.9369 | -1.2163 | -1.3181 |
| Actin | 0.0585 | 0.0032 | 0.0117 | 0.0008 | 0.0659 | 0.0003 | 0.0151 | 0.0001 | 0.0157 | 0.0074 | 0.0019 | 0.0012 | 0.0489 | 0.0002 | 0.0203 | 0.0011 | 0.0103 | 0.0488 |
| Bud | 0.0003 | 0.0002 | 0.0001 | 0 | 0.0005 | 0.0001 | 0.0004 | 0 | 0.0002 | 0.0006 | 0.0002 | 0.0001 | 0.0004 | 0.0001 | 0.0004 | 0.0001 | 0.0001 | 0.0001 |
| Bud Neck | 0.0015 | 0.0006 | 0.0005 | 0.0012 | 0.0017 | 0.0046 | 0.001 | 0.0003 | 0.0006 | 0.0009 | 0.0006 | 0.0026 | 0.0009 | 0.0006 | 0.002 | 0.0005 | 0.0014 | 0.0016 |
| Bud Periphery | 0.0003 | 0.0002 | 0.0001 | 0.0001 | 0.001 | 0.0002 | 0.001 | 0 | 0.0002 | 0.0012 | 0.0003 | 0.0001 | 0.0004 | 0.0001 | 0.0007 | 0.0001 | 0.0002 | 0.0002 |
| Bud Site | 0.0031 | 0.0021 | 0.0008 | 0.0001 | 0.002 | 0.0003 | 0.0032 | 0.0004 | 0.0028 | 0.0021 | 0.0006 | 0.0001 | 0.0017 | 0.0006 | 0.0019 | 0.0004 | 0.0007 | 0.0003 |
| Cell Periphery | 0.0002 | 0.0001 | 0.0001 | 0 | 0.0003 | 0.0001 | 0.0004 | 0 | 0.0001 | 0.0001 | 0.0001 | 0 | 0.0001 | 0.0001 | 0.0001 | 0 | 0.0001 | 0.0001 |
| Cytoplasm | 0.0324 | 0.0476 | 0.0299 | 0.0212 | 0.0461 | 0.0322 | 0.0544 | 0.0572 | 0.0368 | 0.034 | 0.0163 | 0.0385 | 0.0501 | 0.0448 | 0.0571 | 0.0274 | 0.0516 | 0.03 |
| Cytoplasmic Foci | 0.0366 | 0.0133 | 0.0038 | 0.0019 | 0.0253 | 0.0009 | 0.0288 | 0.0013 | 0.0058 | 0.0248 | 0.023 | 0.0022 | 0.0345 | 0.0031 | 0.01 | 0.0068 | 0.0017 | 0.002 |
| Eisosomes | 0.0009 | 0.0001 | 0.0002 | 0.0001 | 0.0018 | 0.0001 | 0.0002 | 0 | 0.0002 | 0.0002 | 0.0002 | 0 | 0.0003 | 0 | 0.0002 | 0.0001 | 0.0003 | 0.0003 |
| Endoplasmic Reticulum | 0.0032 | 0.0037 | 0.0028 | 0.0006 | 0.0032 | 0.0016 | 0.008 | 0.0025 | 0.0025 | 0.0034 | 0.0009 | 0.0009 | 0.0053 | 0.0035 | 0.0033 | 0.0007 | 0.0062 | 0.0022 |
| Endosome | 0.0159 | 0.008 | 0.0037 | 0.002 | 0.0407 | 0.0024 | 0.0355 | 0.0022 | 0.0089 | 0.0041 | 0.0318 | 0.002 | 0.0209 | 0.0039 | 0.0094 | 0.0008 | 0.0129 | 0.0051 |
| Golgi | 0.0098 | 0.0024 | 0.0021 | 0.0015 | 0.0312 | 0.0001 | 0.0078 | 0 | 0.0028 | 0.0016 | 0.0216 | 0.0025 | 0.0068 | 0.0001 | 0.0038 | 0.0001 | 0.002 | 0.0021 |
| Lipid Particles | 0.0457 | 0.0024 | 0.0103 | 0.0024 | 0.0505 | 0.0006 | 0.0175 | 0.0003 | 0.0043 | 0.0095 | 0.0727 | 0.011 | 0.0156 | 0.0006 | 0.0045 | 0.0003 | 0.0029 | 0.0013 |
| Mitochondria | 0.0099 | 0.0052 | 0.0204 | 0.093 | 0.1217 | 0.0006 | 0.0196 | 0.0004 | 0.0103 | 0.0035 | 0.0338 | 0.0006 | 0.0059 | 0.0005 | 0.0118 | 0.0005 | 0.0013 | 0.0009 |
| None | 0.085 | 0.0724 | 0.071 | 0.035 | 0.0695 | 0.0677 | 0.0829 | 0.113 | 0.0766 | 0.0991 | 0.0998 | 0.0768 | 0.044 | 0.0837 | 0.0901 | 0.2066 | 0.1857 | 0.064 |
| Nuclear Periphery | 0.0337 | 0.0368 | 0.0709 | 0.0972 | 0.0337 | 0.0174 | 0.0327 | 0.0282 | 0.0299 | 0.0906 | 0.007 | 0.0069 | 0.028 | 0.0266 | 0.0351 | 0.0577 | 0.0507 | 0.0199 |
| Nucleolus | 0.0097 | 0.0108 | 0.0094 | 0.0061 | 0.0045 | 0.0127 | 0.0053 | 0.0068 | 0.0089 | 0.0115 | 0.0041 | 0.014 | 0.0059 | 0.0079 | 0.0085 | 0.0095 | 0.005 | 0.007 |
| Nucleus | 0.5762 | 0.7438 | 0.7181 | 0.6326 | 0.4325 | 0.8378 | 0.6214 | 0.7625 | 0.7427 | 0.6377 | 0.6627 | 0.8189 | 0.6664 | 0.7419 | 0.6595 | 0.5912 | 0.6389 | 0.7823 |
| Peroxisomes | 0.0222 | 0.0006 | 0.0022 | 0.0008 | 0.0328 | 0.0001 | 0.0219 | 0 | 0.0061 | 0.0302 | 0.0152 | 0.0018 | 0.0173 | 0.0001 | 0.0103 | 0.0001 | 0.0003 | 0.0004 |
| Punctate Nuclear | 0.0519 | 0.0433 | 0.0393 | 0.1012 | 0.0281 | 0.0177 | 0.0343 | 0.0228 | 0.0411 | 0.0342 | 0.0045 | 0.0185 | 0.0413 | 0.0767 | 0.0678 | 0.0953 | 0.0252 | 0.0305 |
| Vacuole | 0.0022 | 0.0022 | 0.0018 | 0.0005 | 0.0022 | 0.002 | 0.0055 | 0.0014 | 0.0027 | 0.0013 | 0.0014 | 0.001 | 0.004 | 0.0044 | 0.0023 | 0.0003 | 0.0014 | 0.0007 |
| Vacuole Periphery | 0.0007 | 0.0008 | 0.0009 | 0.0015 | 0.0045 | 0.0005 | 0.0029 | 0.0004 | 0.0007 | 0.0019 | 0.0012 | 0.0002 | 0.0011 | 0.0006 | 0.0008 | 0.0005 | 0.0011 | 0.0004 |
Sequencing Data
| R1 | R2 | |||||||||
|---|---|---|---|---|---|---|---|---|---|---|
| G1 Post-START | S/G2 | Metaphase | Anaphase | Telophase | G1 Post-START | S/G2 | Metaphase | Anaphase | Telophase | |
| Gene Expression | 12.6524 | 13.6777 | 7.8073 | 10.4947 | 4.9595 | 11.7631 | 10.1062 | 9.8725 | 15.179 | 11.4509 |
| Translational Efficiency | 0.5919 | 0.3721 | 0.8274 | 0.6848 | 1.5191 | 0.6024 | 0.6367 | 0.5546 | 0.3824 | 0.501 |
Hit Data
| Dataset | Hit |
|---|---|
| Protein Concentration | ✘ |
| Protein Localization | ✘ |
| Gene Expression | ✘ |
| Translational Efficiency | ✘ |
Endocytosis
| Temp | Actin Patch (Sac6-tdTomato) | Cortical Patch (Sla1-GFP) | Late Endosome (Snf7-GFP) | Vacuole (Vph1-GFP) |
|---|---|---|---|---|
| 37℃ | ||||
| RT |
Cell Cycle Omics
CYCLoPs (Scc4-GFP)
| Gene / Allele | Actin Patch (Sac6-tdTomato) | Cortical Patch (Sla1-GFP) | Late Endosome (Snf7-GFP) | Vacuole (Sac6-tdTomato) |
|---|
| Gene | Images |
|---|
| Gene | Images |
|---|
Images are not yet available
Images are not yet available